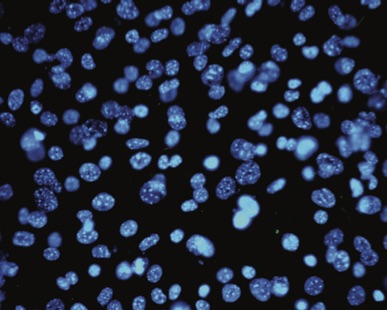
cells close

The Complexity of the Living Cell
Over the last few decades, microbiologists have discovered that each living cell is an unbelievably complex structure. Far from being the simple blob of protoplasm that Darwin envisaged, we now know that its organisation is as complicated as that of a large city with different types of factories, power stations, communication centres, transport systems and storage areas. Every cell is a veritable hive of biochemical activity with carefully differentiated functions controlled by sophisticated information systems. And each one is too small to see with the naked eye!
The human body contains upwards of 50 trillion cells. There are over 200 specialised types such as those that make up muscles, tissue, nerves, glands and skin. Each cell is surrounded by a complex membrane which not only protects it from the outside environment but also regulates the transfer of substances in and out of the cell through microscopic pores.
The human body contains upwards of 50 trillion cells. There are over 200 specialised types such as those that make up muscles, tissue, nerves, glands and skin. Each cell is surrounded by a complex membrane which not only protects it from the outside environment but also regulates the transfer of substances in and out of the cell through microscopic pores.
At the core of the cell is the nucleus. It contains almost all the DNA, packed into the chromosomes which carry a complete set of genetic information. The surface of the nucleus has tiny channels through which can pass the information-carrying chemicals which regulate the functions of the cell.
The rest of the cell, the cytoplasm, contains hundreds of different chemicals and a range of tiny bodies or organelles which are responsible for the many functions of the cell. Among these are the mitochondria which release the energy required by the cell in a controlled chemical reaction. Others store chemicals, release oxygen and dispose of waste materials. There is also a complex internal transport system, composed of tiny tubes which act as pathways along which the materials of the cell are moved as required.
Elsewhere within the cell, fats and proteins are synthesised within the reticulum, a labyrinth of active membranes. Located here are the ribosomes which decode the information carried by the messenger RNA from the nucleus about the specific sequences of amino acids required for the production of the full range of proteins. Proteins are fundamental to all the processes of the cell.
In every respect, the cell is a marvel of miniaturisation and biochemical engineering.
Norman Nevin
Late Emeritus Professor of Medical Genetics
Queens University
Belfast
Northern Ireland
(Prof Nevin was President of the Centre for Intelligent Design until his death in 2014)
Image credits:
Thumbnail - original image © C4ID
Article image - licence to use held by C4ID